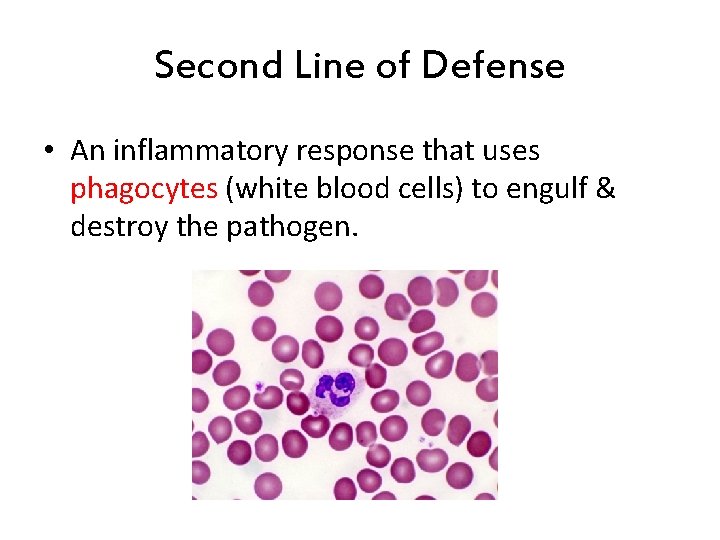
Second Line of Defense • An inflammatory response that uses phagocytes (white blood cells)

Human Body Systems Warm Up 1 How do

Human Body Systems

Warm Up 1. How do muscles & bones work together? 2. Why do they work together?

Skeletal System • Functions: 1. 2. 3. 4. 5. Provides shape & support Helps you move Protects organs Produces blood cells Stores certain materials

Skeletal System • Protects internal organs: – – – Skull … protects the brain Ribs … protect the heart & lungs Vertebrae … protects the spinal cord Femur … produces blood cells in the leg Humerus … produces blood cells in the arm

Organs of the Skeletal System • Bones • Cartilage – Connective tissue that is more flexible than bone – Ex: nose, tops of ears, ends of bones • Ligaments – Hold bones together to form joints

Bone Marrow • Marrow – soft connective tissue found in spaces in bone – Red marrow • Produces the body’s blood cells – Yellow marrow • Stores fat (energy reserve)

THINK… • Describe how this system works with one other system to perform a specific function.

Muscular System • Some functions: 1. Helps the body move 2. Moves food through the digestive system 3. Keeps the heart beating

Muscle Action • Involuntary muscle – Muscles not under your conscious control • Ex: muscles used for breathing & digesting food • Voluntary muscles – Muscles that are under your conscious control • Ex: Smiling, turning the pages in a book, walking to class

3 Types of Muscle Tissue • Skeletal – Attached to bones & move bones using tendons • Connective tissue attaching muscles to bones – Striated, or banded – Voluntary • Smooth – Inside many internal organs – Involuntary – Ex: Stomach • Cardiac – Found only in the heart – Involuntary – Never gets tired (unlike skeletal muscles)

How do muscles work? • Muscles move by contracting, or becoming shorter • Must work in pairs – One contracts, the other returns to its original length

Summary • Explain how these two body systems work together to support homeostasis in humans: and

Integumentary System (Skin) • Functions: 1. Covers and protects the body to prevent water loss and keep out foreign particles. 2. Keeps you in touch with the environment (nerve endings) 3. Regulates your body temperature 4. Gets rid of wastes (sweat/perspiration)

Layers of the Skin • Epidermis – Outermost layer – No nerves or blood vessels – Surface is made of dead cells (provide protection) • Dermis – Lower layer of the skin – Contains nerves, blood vessels, sweat glands, hairs & oil glands

THINK… • Describe how this system works with one other system to perform a specific function.

Nervous System • Functions: 1. Receives information about what is happening inside & outside of the body. 2. Directs the way your body responds to this information. (Remember stimulus and response? ). 3. Helps maintain homeostasis.

Organs of the Nervous System • Brain • Nerves (neurons – nerve cells) • Spinal Cord

Central Nervous System • Brain - controls most functions in the body – Cerebrum • Interprets input from the senses • Controls movement of skeletal muscles • Complex mental processes (learning) – Cerebellum • Coordinates muscle actions & balance – Brainstem (medulla) • Controls involuntary actions (ex: breathing) • Spinal cord - link between brain & the rest of the body

Peripheral Nervous System • Neurons – nerve cell that is specialized to transfer messages in the form of fast-moving electrical energy – electrical messages are called impulses

Peripheral Nervous System • Path of nerve impulse: sensory neuron spinal cord brain spinal cord motor neuron

Summary • Explain how your nervous system might work with your muscular system when you touch a hot pan on the stove.

Respiratory System Why the body needs oxygen…

Respiratory System • Function: – Moves oxygen from the outside environment into the body. – It also removes carbon dioxide and water from the body.

Path of Air into the Body • Path of air into the body: nose pharynx trachea bronchi alveoli

How you breathe: Diaphragm – large dome-shaped muscle used in breathing.

Structure of the Lungs

Transfer Between the Lungs and the Blood

THINK… • Describe how this system works with one other system to perform a specific function.

Circulatory System (aka Cardiovascular System) Function: Carries needed substances to cells and carries wastes away from cells.

• Heart Organs – Hollow, muscular organ that pumps blood throughout the body.

Path of Blood Through the Heart

Organs – Blood Vessels • Arteries – Blood vessel that carries oxygen-rich blood away from the heart and to the body parts. • Capillaries – Small blood vessels where materials are exchanged between the blood and the body’s cells (oxygen & carbon dioxide) • Veins – Carries oxygen-poor blood (w/carbon dioxide) back to the heart (to be pumped out to the lungs)

Flow of Blood Through the Body

Blood Vessels

Blood • Blood is made of 4 components (parts): 1. Plasma – liquid part of blood 2. Red blood cells – take up oxygen in the lungs and deliver it to cells 3. White blood cells – the body’s disease fighters (part of immune system) 4. Platelets – cell fragments used in forming blood clots (that make scabs)

Summary How does the circulatory system help with cellular respiration?

Digestive System • Functions: 1. Breaks down food into molecules the body can use. 2. Molecules are absorbed into the blood & carried throughout the body (by the circulatory system). 3. Wastes are eliminated from the body (by the excretory system)

Roles of Organs • Mouth – mechanical & chemical digestion starts here – Mechanical – physically breaking down food (teeth) – Chemical – breakdown of molecules of food (saliva) • Esophagus – muscular tube connecting the mouth to the stomach – Peristalsis (muscle contraction) moves the food

Roles of Organs • Stomach – Most mechanical digestion takes place – Some chemical with the help of digestive juices (enzymes & acids) • Small Intestine – Most of the chemical digestion takes place – Absorption of nutrients from digested food into the bloodstream

Roles of Organs • Large Intestine – Water is absorbed into the bloodstream – Remaining material is readied for elimination from the body • Rectum – Waste material is compressed into solid form

Path of food through Digestive System mouth esophagus stomach small intestine large intestine rectum eliminated from body

Writing Activity • • R (role) = cheeseburger A (audience) = travel guide readers F (format) = travel log journal entry T (task) = – Describe your journey as you travel through the digestive system. What path do you take? What happens at each stop along the way – ending with the large intestines. No need to share your trip about the excretory process (TMI)…that’s another journey!

Summary • How does the digestive system work with the respiratory system to provide energy for the body?

Excretory System • Function: – Collects wastes produced by cells and removes the wastes from the body.

Organs • Kidneys – Eliminate urea, excess water, & some other waste materials – Filter wastes from the blood – Produce urine

Organs • Anus – Removes solid wastes from digestive system • Lungs – Remove carbon dioxide produced during cellular respiration • Skin – Removes perspiration (dissolved waste materials)

Summary: Respiration & the Human Body Systems The formula and illustrations must be aligned exactly as shown below. Oxygen Respiratory + + Food Energy Wastes ATP + Carbon dioxide + (Energy) Water Glucose Digestive + Circulatory All Body Cells Excretory

Immune System • Function: 1. Provides a barrier against pathogens (disease causing agents). 2. Defends the body against pathogens. • First line of defense: barrier • Second line of defense: inflammatory response • Third line of defense: immune system targets specific pathogens

First Line of Defense (Barriers) • Skin – Chemicals in oil & sweat – Pathogens fall off with dead skin cells • Mucus & cilia – Trap and remove pathogens that enter the respiratory system • Sneezing & coughing – Force pathogens out of the body • Saliva – Destructive chemicals
Second Line of Defense • An inflammatory response that uses phagocytes (white blood cells) to engulf & destroy the pathogen.

Third Line of Defense • The immune system targets specific pathogens. – B-cells • Type of lymphocyte (white blood cell) that produces chemicals called antibodies to destroy each kind of pathogen. – T-cells • Identify pathogens & tell them apart using the pathogen’s antigens (marker molecules)

Preventing Infectious Disease 1. Active immunity – Occurs when a person’s own immune system produces antibodies in response to a pathogen; remembers how to “fight” the pathogen • Two ways to gain active immunity: – – Infection with pathogen Vaccine – weakened or killed pathogen » Ex: chicken pox vaccine 2. Passive immunity – Antibodies are given to the person to fight a disease; their own body did not make them – Ex: rabies

THINK… • Describe how this system works with one other system to perform a specific function.
- Slides: 53